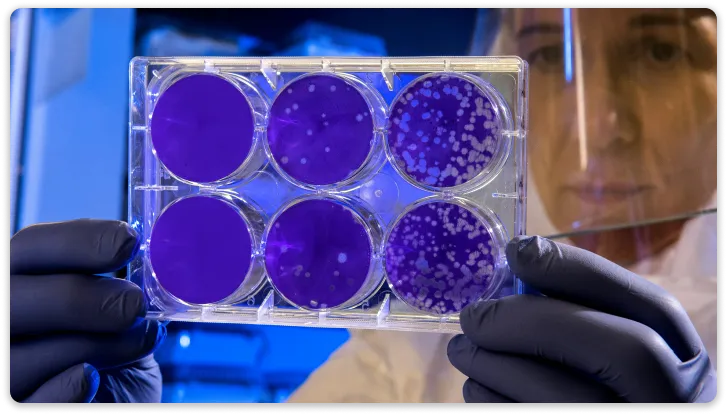

Thank you for participating in this personalized experience. Your responses will not only help determine your current nitric oxide status with an accuracy comparable to test strips, but they will also help Dr. Nathan Bryan develop even more personalized protocols in the future.
These statements have not been evaluated by the Food and Drug Administration. These products are not intended to diagnose, treat, cure, or prevent any disease.
By purchasing N1O1 products, the buyer agrees that the products are for personal use or use by the purchaser only and may not be resold, redistributed, or exported. Unauthorized resale or distribution may lead to legal action, including but not limited to injunctions, seizure of products, and damages. N1O1 enforces its rights against unauthorized resale activities vigorously and will take legal action to protect its intellectual property to the fullest extent of the law.
All company brand names and logos of N1O1 & Pneuma Nitric Oxide LLC are trademarks or registered trademarks of Pneuma Nitric Oxide LLC or its affiliates. Unauthorized use is strictly prohibited.

In an exclusive interview with Xraised, Dr. Nathan S. Bryan—renowned for his pioneering work in nitric oxide research—discussed his groundbreaking product technology that restores nitric oxide production in the body, addressing the root cause of age-related diseases. His innovative approach has led to the creation of products that significantly improve health, including supporting healthy blood pressure, enhancing sexual function, boosting cognition, and optimizing overall performance.





Contact Us